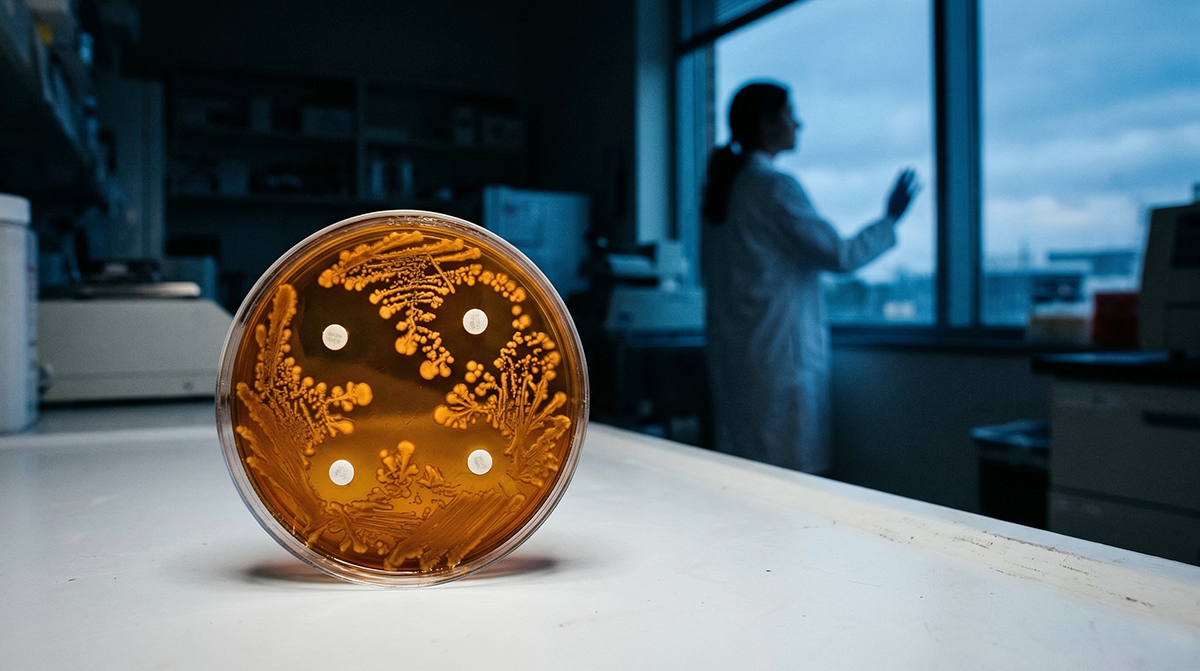

André O. Hudson, Rochester Institute of Technology
Imagine going to the hospital for a bacterial ear infection and hearing your doctor say, “We’re out of options.” It may sound dramatic, but antibiotic resistance is pushing that scenario closer to becoming reality for an increasing number of people. In 2016, a woman from Nevada died from a bacterial infection that was resistant to all 26 antibiotics that were available in the United States at that time.
The U.S. alone sees more than 2.8 million antibiotic-resistant illnesses each year. Globally, antimicrobial resistance is linked to nearly 5 million deaths annually.
Bacteria naturally evolve in ways that can make the drugs meant to kill them less effective. However, when antibiotics are overused or used improperly in medicine or agriculture, these pressures accelerate the process of resistance.
As resistant bacteria spread, lifesaving treatments face new complications – common infections become harder to treat, and routine surgeries become riskier. Slowing these threats to modern medicine requires not only responsible antibiotic use and good hygiene, but also awareness of how everyday actions influence resistance.
Since the inception of antibiotics in 1910 with the introduction of Salvarsan, a synthetic drug used to treat syphilis, scientists have been sounding the alarm about resistance. As a microbiologist and biochemist who studies antimicrobial resistance, I see four major trends that will shape how we as a society will confront antibiotic resistance in the coming decade.
1. Faster diagnostics are the new front line
For decades, treating bacterial infections has involved a lot of educated guesswork. When a very sick patient arrives at the hospital and clinicians don’t yet know the exact bacteria causing the illness, they often start with a broad-spectrum antibiotic. These drugs kill many different types of bacteria at once, which can be lifesaving — but they also expose a wide range of other bacteria in the body to antibiotics. While some bacteria are killed, the ones that remain continue to multiply and spread resistance genes between different bacterial species. That unnecessary exposure gives harmless or unrelated bacteria a chance to adapt and develop resistance.
In contrast, narrow-spectrum antibiotics target only a small group of bacteria. Clinicians typically prefer these types of antibiotics because they treat the infection without disturbing bacteria that are not involved in the infection. However, it can take several days to identify the exact bacteria causing the infection. During that waiting period, clinicians often feel they have no choice but to start broad-spectrum treatment – especially if the patient is seriously ill.
TEK IMAGE/Science Photo Library via Getty Images
But new technology may fast-track identification of bacterial pathogens, allowing medical tests to be conducted right where the patient is instead of sending samples off-site and waiting a long time for answers. In addition, advances in genomic sequencing, microfluidics and artificial intelligence tools are making it possible to identify bacterial species and effective antibiotics to fight them in hours rather than days. Predictive tools can even anticipate resistance evolution.
For clinicians, better tests could help them make faster diagnoses and more effective treatment plans that won’t exacerbate resistance. For researchers, these tools point to an urgent need to integrate diagnostics with real-time surveillance networks capable of tracking resistance patterns as they emerge.
Diagnostics alone will not solve resistance, but they provide the precision, speed and early warning needed to stay ahead.
2. Expanding beyond traditional antibiotics
Antibiotics transformed medicine in the 20th century, but relying on them alone won’t carry humanity through the 21st. The pipeline of new antibiotics remains distressingly thin, and most drugs currently in development are structurally similar to existing antibiotics, potentially limiting their effectiveness.
To stay ahead, researchers are investing in nontraditional therapies, many of which work in fundamentally different ways than standard antibiotics.
One promising direction is bacteriophage therapy, which uses viruses that specifically infect and kill harmful bacteria. Others are exploring microbiome-based therapies that restore healthy bacterial communities to crowd out pathogens.
Researchers are also developing CRISPR-based antimicrobials, using gene-editing tools to precisely disable resistance genes. New compounds like antimicrobial peptides, which puncture the membranes of bacteria to kill them, show promise as next-generation drugs. Meanwhile, scientists are designing nanoparticle delivery systems to transport antimicrobials directly to infection sites with fewer side effects.
Beyond medicine, scientists are examining ecological interventions to reduce the movement of resistance genes through soil, wastewater and plastics, as well as through waterways and key environmental reservoirs.
Many of these options remain early-stage, and bacteria may eventually evolve around them. But these innovations reflect a powerful shift: Instead of betting on discovering a single antibiotic to address resistance, researchers are building a more diverse and resilient tool kit to fight antibiotic-resistant pathogenic bacteria.
3. Antimicrobial resistance outside hospitals
Antibiotic resistance doesn’t only spread in hospitals. It moves through people, wildlife, crops, wastewater, soil and global trade networks. This broader perspective that takes the principles of One Health into account is essential for understanding how resistance genes travel through ecosystems.
Researchers are increasingly recognizing environmental and agricultural factors as major drivers of resistance, on par with misuse of antibiotics in the clinic. These include how antibiotics used in animal agriculture can create resistant bacteria that spread to people; how resistance genes in wastewater can survive treatment systems and enter rivers and soil; and how farms, sewage plants and other environmental hot spots become hubs where resistance spreads quickly. Even global travel accelerates the movement of resistant bacteria across continents within hours.
Together, these forces show that antibiotic resistance isn’t just an issue for hospitals – it’s an ecological and societal problem. For researchers, this means designing solutions that cross disciplines, integrating microbiology, ecology, engineering, agriculture and public health.
4. Policies on what treatments exist in the future
Drug companies lose money developing new antibiotics. Because new antibiotics are used sparingly in order to preserve their effectiveness, companies often sell too few doses to recoup development costs even after the Food and Drug Administration approves the drugs. Several antibiotic companies have gone bankrupt for this reason.
To encourage antibiotic innovation, the U.S. is considering major policy changes like the PASTEUR Act. This bipartisan bill proposes creating a subscription-style payment model that would allow the federal government up to US$3 billion to pay drug manufacturers over five to 10 years for access to critical antibiotics instead of paying per pill.
Global health organizations, including Médecins Sans Frontières (Doctors Without Borders), caution that the bill should include stronger commitments to stewardship and equitable access.
Still, the bill represents one of the most significant policy proposals related to antimicrobial resistance in U.S. history and could determine what antibiotics exist in the future.
The future of antibiotic resistance
Antibiotic resistance is sometimes framed as an inevitable catastrophe. But I believe the reality is more hopeful: Society is entering an era of smarter diagnostics, innovative therapies, ecosystem-level strategies and policy reforms aimed at rebuilding the antibiotic pipeline in addition to addressing stewardship.
For the public, this means better tools and stronger systems of protection. For researchers and policymakers, it means collaborating in new ways.
The question now isn’t whether there are solutions to antibiotic resistance – it’s whether society will act fast enough to use them.![]()
André O. Hudson, Dean of the College of Science, Professor of Biochemistry, Rochester Institute of Technology
This article is republished from The Conversation under a Creative Commons license. Read the original article.

0 Comments